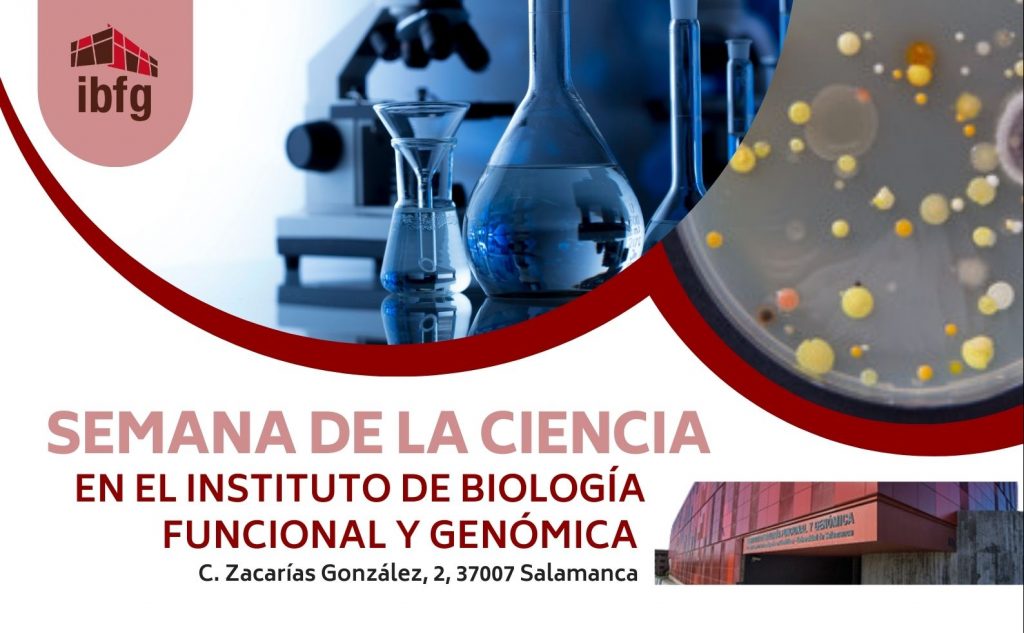

Esta iniciativa está totalmente arraigada ya en nuestra ciudad, que cuenta con una buena muestra de actividades de divulgación de la ciencia. Hoy nos hemos acercado al Instituto de Biología Funcional y Genómica, un centro mixto de la USAL y el CSIC. Hablamos con la investigadora, también profesora de la USAL, Beatriz Santos Romero.
Este jueves ya comienzan los eventos, con una visita guiada al IBFG de los alumnos del IES Senara de Babilafuente. En la tradicional Yincana habrá que investigar un crimen. Toda la información sobre las actividades se proponen las pueden encontrar en la página del IBFG.
Beatriz Santos, además de hablarnos de todos los eventos de la Semana de la Ciencia, nos contaba sobre la divulgación que realiza prácticamente en todos los meses del año el Instituto de Biología Funcional y Genómica, sobre el nacimiento de la Semana de la Ciencia y su principal objetivo: hacer llegar la ciencia a la sociedad.